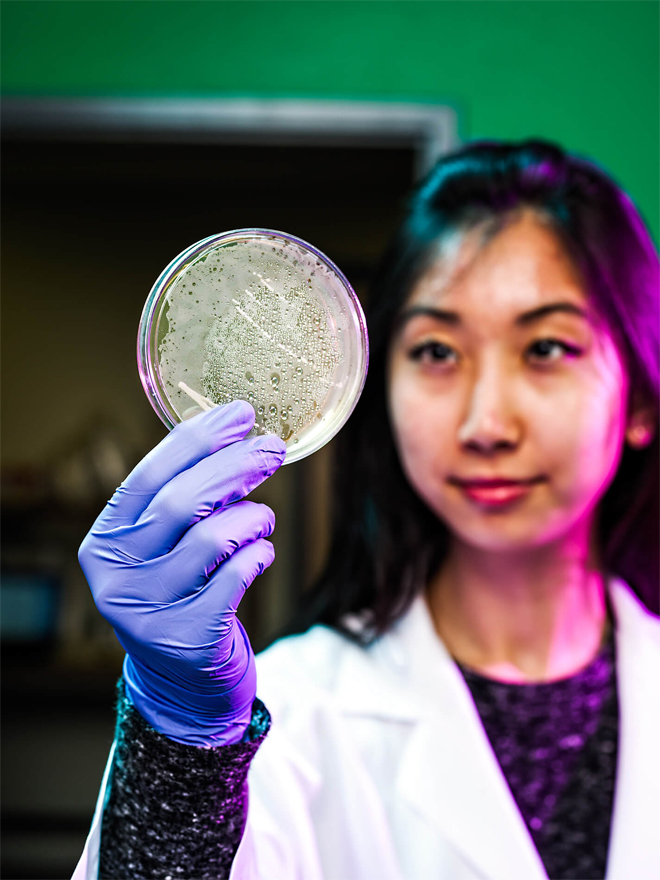

สุดทึ่ง! สาวจีน วัย22 ใช้เวลา5ปี ก่อตั้ง Startup มูลค่า 2 ล้านดอลล่าร์
สำหรับวันนี้เราจะพาผู้อ่านทุกท่านไปทำความรู้จักกับสาวน้อยมหัศจรรย์ชื่อว่า Cathy Tie สาวชาวจีนที่ไปเติบโตต่างถิ่นอย่างที่โตรอนโต แม้จะไม่ได้เติบโตในบ้านเกิดแต่เธอก็สร้างชีวิตที่ดีสมบูรณ์เลิศได้ เรื่องราวจะเป็นยังไงตาม www.ThaiSMEsCenter.com มาอ่านกัน
Cathy Tie ในวัย 22 ปี ประสบความสำเร็จมากกว่าคนอื่นๆ งานวิจัยเกี่ยวกับจีโนมิกส์ (Genomics) ของเธอได้รับการตีพิมพ์ในวารสารวิทยาศาสตร์ เธอก่อตั้งบริษัททดสอบทางพันธุกรรม ที่ทำกำไรได้และเพิ่งจนกลายเป็นหุ้นส่วนที่อายุน้อยที่สุด ที่เข้าร่วมทุน Palo Alto-based VC firm Cervin Ventures ของบริษัท Silicon Valley
ภาพจาก goo.gl/images/QVh3Fh , goo.gl/images/j4fpB6
แต่สำหรับ Tie นี่เป็นเพียงจุดเริ่มต้นเท่านั้น Tie ย้ายจากจีนไปโตรอนโตกับพ่อแม่เมื่อเธออายุได้ 4 ขวบ เธอเป็นเด็กที่มีพรสวรรค์ และเมื่อถึงเวลาที่เธอเข้าเรียนในโรงเรียนมัธยมแล้ว ความสนใจที่ลึกซึ้งของเธอในด้านชีววิทยาและเคมีเกินกว่าในห้องเรียน “การทำวิจัยนอกโรงเรียนด้วยตัวเองกลายเป็นลักษณะเด่นของฉัน” Tie กล่าว
ภาพจาก goo.gl/images/34JBjd
เธอฉลาดพอที่จะรู้ว่าเธอจำเป็นต้องเข้าร่วมเครือข่ายของอาจารย์วิทยาลัย และนักวิจัยเพื่อช่วยชี้นำการวิจัยของเธอ พอเธอขึ้นปีที่ 2 เธอเริ่มโทรรบกวนอาจารย์ คณะวิทยาศาสตร์ของมหาวิทยาลัยมากขึ้น เกี่ยวข้องกับงานวิจัยสองเซลล์โปรตีนในเซลล์เม็ดเลือดขาวมันช่วยป้องกันภูมิคุ้มกันของร่างกาย
ภาพจาก goo.gl/images/w8RzSv
“ฉันโทรหา อาจารย์มหาวิทยาลัยโดยตรง แต่ทุกคนก็ปฏิเสธงานวิจัยฉัน” จนในที่สุดศาสตราจารย์ แผนกภูมิคุ้มกันวิทยา มหาวิทยาลัยโตรอนโต ก็ตกลงที่จะรับเด็กอายุ 15 ปี มาทำวิจัยที่ห้องทดลองของวิทยาลัย “หลังเลิกเรียนฉันจะเดินไปที่ห้องแล็บ และจะอยู่ที่นั่นจนถึง 1 หรือ 2 ทุ่ม” เธอกล่าว
ภาพจาก goo.gl/images/miKAm9
ในที่สุดเมื่ออายุ 16 ปี ความพยายามก็ส่งผล ผลงานวิจัยของ Tie ได้ตีพิมพ์ใน Canadian Young Scientists Journal และ Genome Research หลังจากเรียนจบจาก high school เธอลงทะเบียนเรียนในมหาวิทยาลัยโตรอนโตเพื่อศึกษาประวัติความเป็นมา แต่เธอก็เรียนไม่จบปี
เพราะขณะที่เธอกำลังเรียนและทำวิจัยเกี่ยวกับยีนที่หายากในห้องปฏิบัติการของมหาวิทยาลัย เธอมีความคิดว่าเธอต้องการเริ่มต้นบริษัทที่มุ่งเน้นการทดสอบทางพันธุกรรมที่ถูกต้องและประเมินความเสี่ยงต่อโรคได้ดีขึ้น
Tie ร่วมมือกับนักศึกษาปริญญาเอก Leo Wan ผู้ซึ่งกำลังทำการวิจัยที่ห้องปฏิบัติการพันธุศาสตร์ ระดับโมเลกุล ชื่อของบริษัทสตาร์ทอัพที่เธอตั้งขึ้นคือ “Ranomics” เป็นการรวมคำสองคำคือ “rare” และ “genomics” ในช่วงต้นปี ค.ศ.2015
ภาพจาก goo.gl/images/zwwj7E
บริษัทได้รับเงิน 100,000 ดอลล่าร์ จากการระดมทุนของ San Francisco-based biotechnology accelerator และ IndieBio ซึ่งเป็นสำนักงานให้คำปรึกษาและห้องปฏิบัติการ “ในนั้นมีนักลงทุนจำนวนมากที่สนใจในตัวบริษัท” Tie กล่าว ดังนั้นบริษัทจึงระดมทุนเพิ่มได้อีก 2 ล้านดอลล่าร์ และเริ่มเปิดบริษัทเมื่อ ค.ศ. 2015 Tie ได้ย้ายบริษัทกลับมาที่โตรอนโต
ได้ขยายทีมและรายชื่อลูกค้าของเธอ จนมาถึงปัจจุบัน บริษัท Ranomics ได้วิเคราะห์เซลล์กลายพันธุ์แล้วกว่า 2,000 เซลล์ (เซลล์มะเร็งเต้านม, มะเร็งลำไส้ใหญ่ และมะเร็งต่อมลูกหมาก ) เมื่อธุรกิจไปได้ดี Tie ตัดสินใจที่จะลงทุนอีกครั้งกับบริษัท Palo Alto-based VC firm Cervin Ventures
ภาพจาก www.cervinventures.com
ในที่สุด Tie ย้ายไปที่ Silicon Valley เพื่อร่วมเป็นหุ้นส่วนของ VC เธอยังคงเป็นกรรมการของ Ranomics จนถึงตอนนี้เธอชอบประสบการณ์ทำงานที่ VC แต่เธอยอมรับว่าเป็นเส้นทางการเรียนรู้ที่ค่อนข้างยาก
จบไปแล้วกับเรื่องราวของสาวน้อยมหัศจรรย์ ที่ถึงแม้เรียนไม่จบมหาวิทยาลัยก็มีบริษัทของตัวเอง ได้ทำสิ่งที่ตัวเองสนใจได้อย่างเต็มที่ เพราะเธอไม่เคยกลัว มีความพยายาม, ความทะเยอทะยาน และไม่เกลียดการเรียนรู้ เธออาจเป็นคนมีพรสวรรค์ในเรื่องการทำวิจัยตั้งแต่อายุ 18 ปี อีกทั้งยังเป็นหุ้นส่วนของบริษัทใหญ่อย่าง VC ด้วย
อ่านบทความอื่นๆ จากไทยแฟรนไชส์เซ็นเตอร์ bit.ly/2AywOvr
เลือกซื้อแฟรนไชส์ไทยขายดี ทำธุรกิจ bit.ly/2Jatqq2
ที่มา: cnnmon.ie/2AXgyEP , bit.ly/2vuPBCX , bit.ly/2M8BwWs